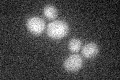
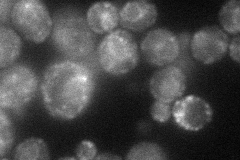
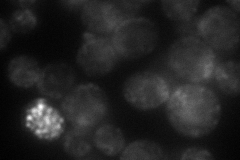

View description
Pheromone-regulated protein with 3 predicted transmembrane segments and an FF sequence, a motif involved in COPII binding; member of DUP240 gene family
Localization:
Intensity:
Fold change:
Significance:
-
C’ GFP library in SD
below threshold14.22 -
N' NOP1pr-GFP in SD
ER,punctate44.032 -
N' TEF2pr-mCherry in SD
ER,punctate51.9214 -
N' NATIVEpr-GFP in SD

below threshold12.7302 -
N' TEF2pr-VC and Cyto-VN in SD

below threshold25.4748 -
C’ GFP library in SD+DTT

cytosol13.240.93No -
C’ GFP library in SD+H2O2

cytosol14.981.05No -
C’ GFP library in Starvation Media

cytosol14.631.02No -
C’ GFP library on the background of Pup2-DaMP

below threshold -
C’ GFP library on the background of CCT mutant

below threshold15.51691.09062No
